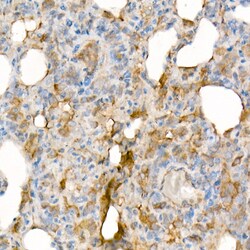
Invitrogen IL-15 Recombinant Rabbit Monoclonal Antibody (6R10Y9) 100 &mu;L;

missing translation for 'onlineSavingsMsg'
Learn More
Learn More
Invitrogen™ IL-15 Recombinant Rabbit Monoclonal Antibody (6R10Y9)
Rabbit Recombinant Monoclonal Antibody
Brand: Invitrogen™ MA555211
This item is not returnable.
View return policy
Description
Immunogen Sequence: NWVNVISDLK KIEDLIQSMH IDATLYTESD VHPSCKVTAM KCFLLELQVI SLESGDASIH DTVENLIILA NNSLSSNGNV TESGCKECEE LEEKNIKEFL QSFVHIVQMF INTS.
IL-15 (Interleukin 15 ) is a cytokine that regulates T and natural killer cell activation and proliferation. IL-15 and IL-2 share many biological activities as both have been found to bind common hematopoietin receptor subunits, and may compete for the same receptor, and thus negatively regulate each other's activity. The number of CD8+ memory cells is shown to be controlled by a balance between IL-15 and IL-2. IL-15 induces the activation of JAK kinases, as well as the phosphorylation and activation of transcription activators STAT3, STAT5, and STAT6. In mouse, studies suggest that IL-15 may increase the expression of apoptosis inhibitor Bcl-xL, possibly through the transcription activation activity of STAT6, and thus prevent apoptosis. IL-15 plays an important role in the growth and differentiation of T and B lymphocytes, natural killer cells, macrophages, and monocytes as well as activation of a number of important intracellular signaling molecules. As such, IL-15 could be essential for the immune responses, allograft rejection, and the pathogenesis of autoimmune diseases. Further, IL-15 is a widely expressed pro-inflammatory cytokine and has been shown to play a role in several inflammatory disorders, including rheumatoid arthritis, psoriasis and pulmonary inflammatory diseases. Emerging data suggest that IL-15 may serve as a good therapeutic target, as there appears to be a beneficial effect of IL-15 neutralization in models of psoriasis and diabetes.
Specifications
| IL-15 | |
| Recombinant Monoclonal | |
| 0.5 mg/mL | |
| PBS with 0.05% BSA, 50% glycerol and 0.05% ProClin 300; pH 7.3 | |
| P40933, P48346, P97604 | |
| IL15 | |
| Recombinant protein (or fragment). | |
| 100 μL | |
| Primary | |
| Human, Mouse, Rat | |
| Antibody | |
| IgG |
| ELISA, Immunohistochemistry (Paraffin) | |
| 6R10Y9 | |
| Unconjugated | |
| IL15 | |
| AI503618; il 15; Il15; IL-15; ILN; Interleukin; interleukin 15; Interleukin15; interleukin-15; MGC9721; M-IL-15 | |
| Rabbit | |
| Protein A | |
| RUO | |
| 16168, 25670, 3600 | |
| -20°C, Avoid Freeze/Thaw Cycles | |
| Liquid |
Product Content Correction
Your input is important to us. Please complete this form to provide feedback related to the content on this product.
Product Title
Spot an opportunity for improvement?Share a Content Correction